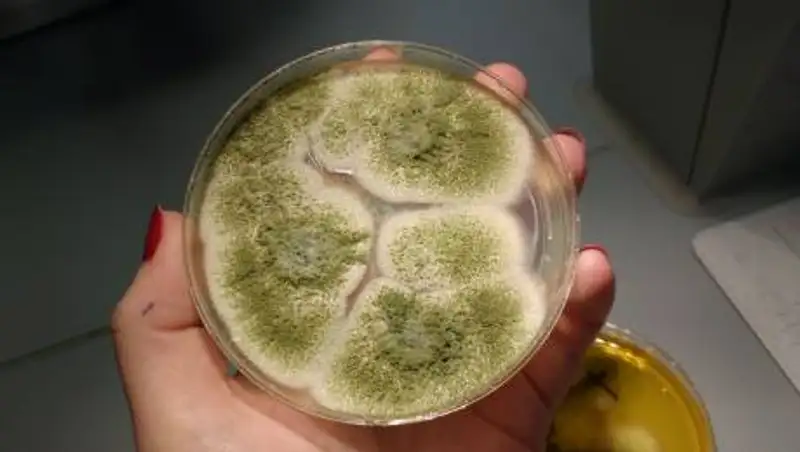

"Черная плесень" из Индии добралась до России
csn-tv.ru
csn-tv.ru
Грибковая инфекция распространена во многих странах.
В России зафиксированы случаи заражения индийской "черной плесенью", сообщает zakon.kz.
Речь идет о редкой грибковой инфекции - мукормикозе.
По данным "Известий", эта инфекция поражает нос, глаза и органы дыхания.
Болезнь развивается в полости носа и придаточных пазухах, а также вторично распространяется в глазницы. На пораженных участках из-за некроза ткани возникает характерный черный струп, особенно выраженный на коже в области носа, - отмечается в публикации.
Как уточнил заведующий кафедрой клинической микологии, аллергологии и иммунологии СЗГМУ им. И.И. Мечникова Николай Климко, эту проблему нельзя назвать чисто индийской. Заболевание встречается во всех странах.
В России мукормикоз встречается редко. Сейчас один такой пациент лечится в микологической клинике, надеюсь, у него все будет хорошо, - сказал ученый.
По его словам, в первую очередь мукормикоз опасен для людей с подавленным иммунитетом.
У больных COVID-19 инфекция развивается обычно на фоне декомпенсированного сахарного диабета. В Индии заболеваемость высока именно из-за большого количества пациентов с этим недугом, - заключил врач.
Читайте также:
Поделитесь новостью
Читайте также
Если вы видите данное сообщение, значит возникли проблемы с работой системы комментариев. Возможно у вас отключен JavaScript













